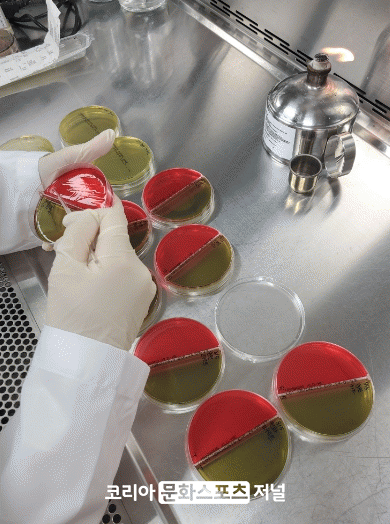

|
МіАХАЫЛч ДыЛѓРК ЙЋРлРЇЗЮ МБСЄЕШ УрЛъЙА СІСЖЁЄЦЧИХОїМв 27АГМвЗЮ, ЕПЙАРЇЛ§НУЧшМвАЁ СїСЂ МіАХЧи АЫЛчЧбДй. АЫЛч ЧзИёРК ЛьИ№ГкЖѓ, ДыРхБе, ИЎНКХзИЎОЦ Ею СжПф НФСпЕЖБе 5СОАњ КИСИЗсЁЄХИИЃЛіМв Ею НФЧА УЗАЁЙАРЬДй.
АЫЛч АсАњ КЮРћЧе ЦЧСЄ НУ НФЧАРЧОрЧАОШРќУГ Ею АќАшБтАќПЁ ОЫИЎАэ СІСЖЁЄЦЧИХОїУМПЁ НХМгЧЯАд ХыКИЧи ЧиДч СІЧА РЏХыРЛ СяНУ ТїДмЧв АшШЙРЬДй.
СЄСіПЕ РќГВЕЕЕПЙАРЇЛ§НУЧшМвРхРК ЁАЧГПфЗЮПю УпМЎРЛ ИТОЦ ЕЕЙЮРЬ ОШНЩЧЯАэ ЕхНУЕЕЗЯ УрЛъНФЧА ОШРќМК АЫЛчИІ С§Сп НЧНУЧЯАкДйЁБИч ЁАУрЛъЙА СІСЖЁЄЦЧИХОї АќАшРкВВМДТ АэПТДйНРЧб НУБтРЬДЯ УрЛъЙА УыБоЁЄКИАќ НУ РЇЛ§АќИЎИІДѕПэ УЖРњШї ЧиДоЖѓЁБАэ ДчКЮЧпДй.
РќГВСіПЊ УрЛъЙА АЫЛчИІ УЅРгСіАэ РжДТ РќГВЕЕЕПЙАРЇЛ§НУЧшМвДТ ИХГт НФЧАРЧОрЧАОШРќУГАЁ НЧНУЧЯДТ УрЛъЙА НУЧшЁЄАЫЛч ДЩЗТ ЦђАЁПЁМ ПЌМг РћАнБтАќРИЗЮ МБСЄЕЦДй. УрЛъЙА ЦЧИХЁЄСІСЖОїУМИІ ДыЛѓРИЗЮ ПЌАЃ 1ИИ 8УЕ АЧРЧ УрЛъЙА ОШРќМК АЫЛчИІ ЧЯАэ РжДй.
ТїЧрПю КЛКЮРх
 2026.02.17(Ш) 20:14
2026.02.17(Ш) 20:14